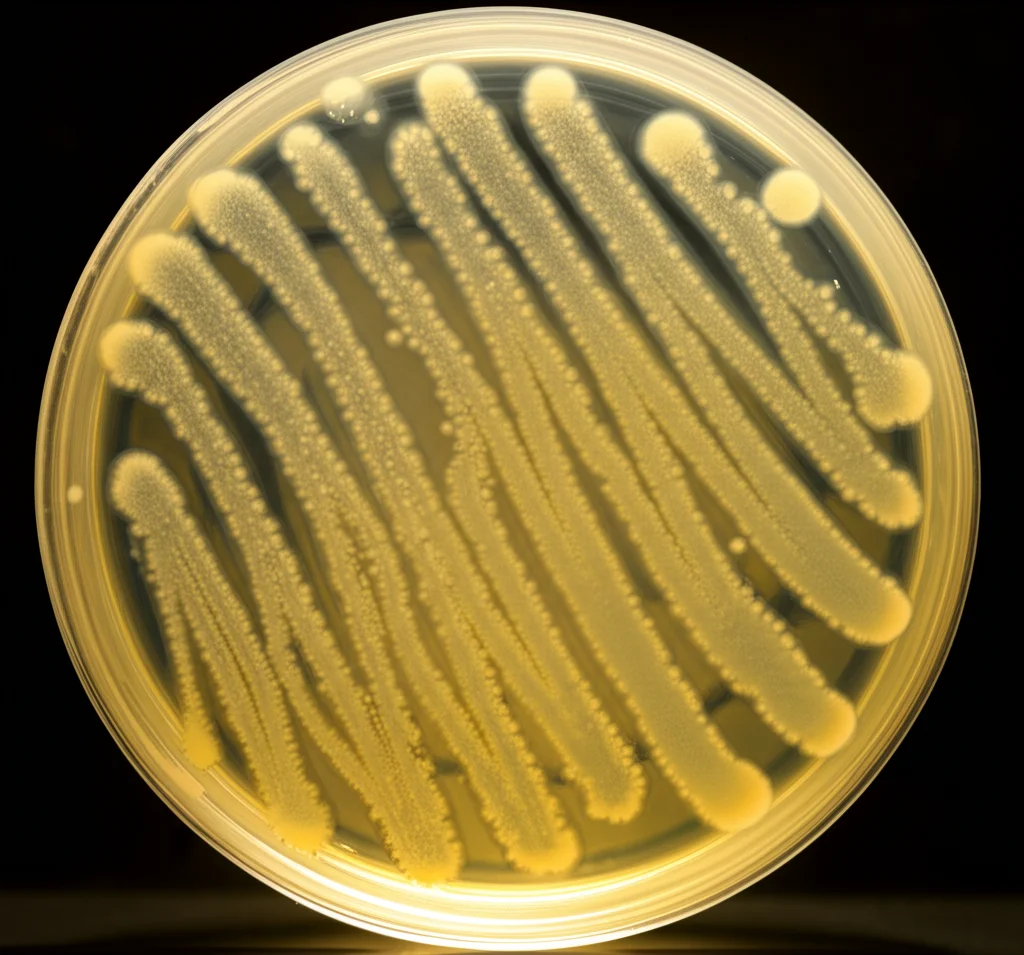
Fotografia macro di colonie batteriche del genere Bacillus su una piastra di Petri in laboratorio, illuminazione controllata, obiettivo macro 100mm, alta definizione dei dettagli delle colonie, messa a fuoco precisa.

Bacillus aryabhattai: Il Super Probiotico Segreto per Galline più Forti e Uova al Top!
Ciao a tutti! Oggi voglio parlarvi di una scoperta che mi ha davvero entusiasmato nel mondo dell’allevamento, in particolare quello delle nostre amiche galline ovaiole. Sapete, siamo sempre alla ricerca di modi naturali ed efficaci per migliorare la salute degli animali e la qualità di ciò che producono, dicendo magari addio (o arrivederci) a un uso eccessivo di antibiotici. E qui entrano in gioco i probiotici!
Questi microrganismi “buoni” sono come dei piccoli supereroi per l’intestino. Aiutano a mantenere tutto in equilibrio, migliorano la digestione, rinforzano il sistema immunitario e possono persino rendere la carne e le uova di qualità superiore. Nel mondo avicolo, nomi come Lactobacillus, Bifidobacterium e Saccharomyces sono già abbastanza noti. Ma la ricerca non si ferma mai, vero?
Alla Ricerca del Probiotico Perfetto: Un’Avventura Inaspettata
La cosa affascinante di questo studio è da dove sono andati a cercare i nuovi candidati probiotici. Non solo nei soliti posti, come le feci di pollo, ma anche in ambienti decisamente più… esotici! Immaginate ricercatori che raccolgono campioni dall’intestino di granchi (come il granchio di fango e il granchio blu), gamberetti (il gambero banana!), e persino dal fango di stagni di gamberetti e dal terreno vicino a sorgenti termali in Tailandia. L’idea? Gli organismi che prosperano in ambienti difficili potrebbero avere sviluppato capacità uniche, magari una super resistenza o proprietà antimicrobiche speciali, utili anche per le nostre galline. Geniale, no?
Da questa caccia al tesoro microbiologica, sono stati isolati 11 ceppi batterici che sembravano appartenere al genere Bacillus. Perché proprio i Bacillus? Perché sono dei duri! Producono spore, delle specie di “capsule di sopravvivenza” che li rendono super resistenti al calore, ai processi di produzione del mangime e alle condizioni difficili dello stomaco e dell’intestino. Praticamente perfetti per essere aggiunti al cibo delle galline.
Le Prove del Nove: Sopravvivenza e Sicurezza
Una volta isolati questi candidati, è iniziata la selezione vera e propria. Come in un talent show, i batteri dovevano dimostrare di avere le carte in regola.
- Efficienza di Sporulazione: Quanto sono bravi a creare quelle spore resistenti? Quattro ceppi hanno superato il 70%, con punte oltre l’80%! Tra questi, il nostro protagonista: CKNJh11.
- Sicurezza Prima di Tutto: Fondamentale verificare che non fossero resistenti agli antibiotici comuni (non vogliamo certo diffondere l’antibiotico-resistenza!) e che non fossero pericolosi, ad esempio causando emolisi (la rottura dei globuli rossi). I ceppi migliori, incluso CKNJh11, si sono dimostrati sensibili a molti antibiotici e non emolitici (tipo gamma-emolisi, considerata sicura).
- Resistenza da Campioni: Il test più duro! I batteri dovevano dimostrare di poter sopravvivere al passaggio nello stomaco (ambiente super acido) e nell’intestino (ricco di sali biliari). E qui, il ceppo CKNJh11 ha brillato, mostrando un’ottima tolleranza sia ai succhi gastrici artificiali (anche a pH molto bassi) sia ai sali biliari. Un vero Rambo dei microbi!
L’Identikit del Campione: Ecco *Bacillus aryabhattai* CKNJh11
Dopo tutte queste prove, il ceppo CKNJh11 è emerso come il candidato più promettente. Ma chi era veramente? Grazie all’analisi del suo DNA (in particolare del gene 16S rRNA e del gene gyrA, utile per distinguere specie simili), è stato identificato con certezza: si trattava di Bacillus aryabhattai. Un nome un po’ esotico, vero? Deriva da Aryabhata, un antico astronomo e matematico indiano. Anche se già conosciuto, non era stato studiato a fondo per questo specifico utilizzo nelle galline ovaiole.
Sul Campo: La Prova con le Galline Ovaiole
Identificato il nostro campione, era ora di vedere cosa sapeva fare “sul campo”. Hanno preso 300 galline ovaiole Hy-Line Brown di 23 settimane e le hanno divise in tre gruppi per 6 settimane:
- Gruppo di Controllo (T0): Dieta normale.
- Gruppo T1: Dieta normale + B. aryabhattai CKNJh11 (1 milione di spore per 100g di mangime).
- Gruppo T2: Dieta normale + B. aryabhattai CKNJh11 incapsulato (100 milioni di spore per 100g di mangime). L’incapsulamento è una tecnica per proteggere ulteriormente le spore.
Hanno monitorato attentamente la crescita delle galline e, ovviamente, la qualità delle uova prodotte.
Risultati Sorprendenti: Crescita e Uova Migliori
E qui arriva il bello! Dopo 6 settimane, cosa è successo?
Le galline che avevano ricevuto il probiotico, specialmente quelle del gruppo T2 (dose più alta e incapsulata), hanno mostrato un aumento di peso significativamente maggiore rispetto al gruppo di controllo (4.83% di aumento per T2, 4.00% per T1, contro il 2.91% del controllo). Non male!
Ma la vera chicca riguarda le uova. Pur non essendoci state differenze enormi su tutti i parametri (peso dell’uovo totale, colore del tuorlo, unità Haugh ecc.), un dato è saltato all’occhio: il peso del guscio! Le galline trattate con B. aryabhattai CKNJh11 (sia T1 che T2) producevano uova con un guscio significativamente più pesante (e quindi più robusto) rispetto alle galline del gruppo di controllo. Il gruppo T1 ha avuto i risultati migliori su questo specifico parametro (6.33g contro i 6.14g di T2 e i valori inferiori del controllo).

Perché Funziona? Un Intestino Felice Fa Uova Forti
Come fa un batterio nell’intestino a rendere il guscio dell’uovo più forte? Sembra strano, ma c’è una logica. I probiotici come B. aryabhattai migliorano la salute generale dell’intestino. Un intestino sano assorbe meglio i nutrienti dal cibo, incluso il calcio, che è il mattone fondamentale per costruire un guscio d’uovo robusto. Inoltre, un buon equilibrio della flora intestinale (il microbiota) aiuta a tenere a bada i batteri “cattivi”, riduce le infiammazioni e permette alla gallina di “spendere” le sue energie e risorse per produrre uova di qualità, invece che per combattere infezioni.
Pensateci: un ambiente intestinale ottimale, grazie ai probiotici, significa migliore digestione, maggiore assorbimento di minerali essenziali come il calcio, e una gallina più sana e produttiva. Ecco spiegato l’aumento di peso e, soprattutto, il guscio più pesante!
Un Futuro Promettente per le Nostre Galline
Insomma, questo studio ci mostra come Bacillus aryabhattai CKNJh11, isolato da fonti ambientali inaspettate, sia un candidato probiotico davvero promettente per le galline ovaiole. Ha dimostrato di essere sicuro, resistente e capace di migliorare sia la crescita delle galline sia, in modo significativo, la qualità del guscio delle uova.
Certo, come dicono gli stessi ricercatori, c’è ancora strada da fare. Bisognerà capire ancora meglio i meccanismi precisi con cui agisce questo specifico ceppo (magari con studi in vitro) e ottimizzare le tecniche, come l’incapsulamento, per massimizzare i benefici a lungo termine.
Ma la direzione è quella giusta: sfruttare le incredibili potenzialità dei microrganismi “buoni” per un allevamento più sostenibile, più rispettoso del benessere animale e capace di darci prodotti finali, come le uova, di qualità sempre migliore. E tutto grazie a un piccolo batterio “scoperto” quasi per caso in un granchio o nel fango! Non è affascinante?
Fonte: Springer
